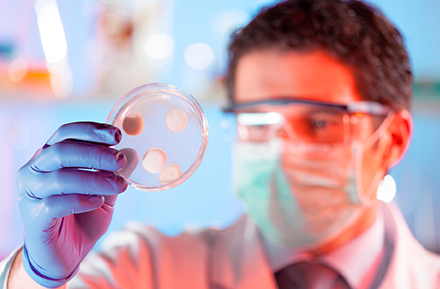

| Ao continuar navegando, você concorda com a nossa Política de Privacidade e Termos de Uso. |
| Ao continuar navegando, você concorda com a nossa Política de Privacidade e Termos de Uso. |
Bem vindo ao nosso site! |
-
Seja bem-vindo ao Laboratório Proxy, seu parceiro estratégico de referência no atendimento à empresas de Segurança e Higiene Ocupacional. Especializados em oferecer serviços personalizados de análises químicas, trabalhamos incansavelmente para ser o apoio técnico e científico que essas empresas necessitam. Nossa missão é apoiá-las na manutenção de ambientes de trabalho seguros e saudáveis, contribuindo diretamente para o bem-estar de seus colaboradores.
Unindo inovação e qualidade superior, proporcionamos soluções abrangentes que atendem a uma variedade de necessidades. Desde análises laboratoriais meticulosas até calibração precisa de equipamentos, nosso portfólio de serviços é desenvolvido para superar expectativas.
Entre em contato conosco hoje mesmo para saber mais sobre como podemos atender às suas necessidades e ajudar sua empresa a prosperar no campo da Segurança e Higiene Ocupacional.
-

Serviços Oferecidos |
Descubra o que o Laboratório Proxy pode fazer por você! Somos especialistas em Análises Químicas para Higiene Ocupacional e Locação de Equipamentos, e nos empenhamos em atender às suas necessidades com precisão e qualidade.
Vantagens e Diferenciais |
No Laboratório Proxy, nós nos destacamos por quatro principais características: a agilidade na entrega dos resultados das análises, a confiabilidade de um laboratório próprio supervisionado por um químico responsável, a utilidade do levantamento das FISPQ's para garantir a segurança do produto e o suporte técnico especializado que oferecemos para as coletas. Esses são os diferenciais que nos permitem fornecer um serviço excepcional para nossos clientes.
Parceiros |